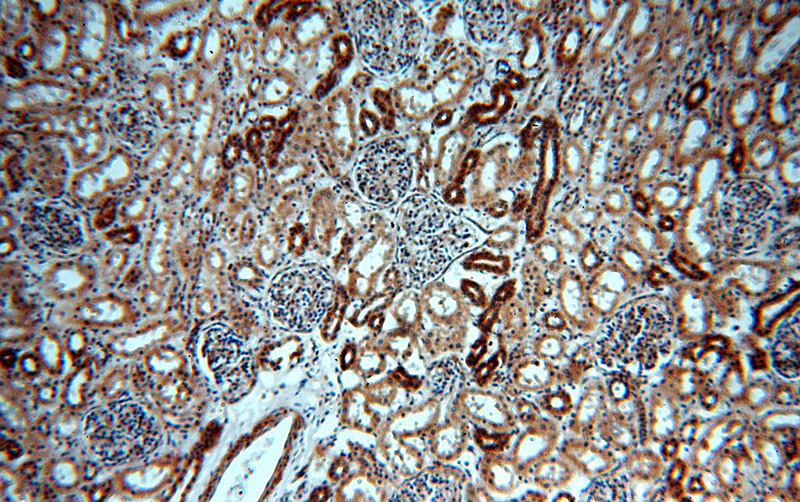
Immunohistochemical of paraffin-embedded human kidney using Catalog No:107780(ADCY3 antibody) at dilution of 1:100 (under 10x lens)
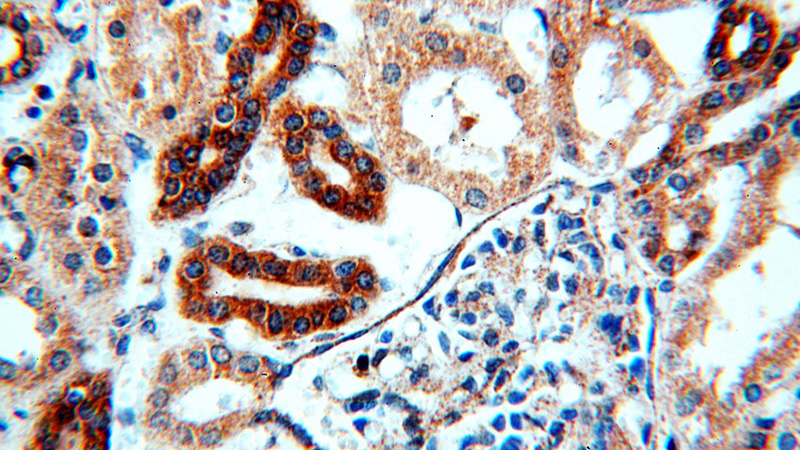
Immunohistochemical of paraffin-embedded human kidney using Catalog No:107780(ADCY3 antibody) at dilution of 1:100 (under 40x lens)

-
Product Name
ADCY3 antibody
- Documents
-
Description
ADCY3 Rabbit Polyclonal antibody. Positive IHC detected in human kidney tissue, human heart tissue. Positive IF detected in MDCK cells, HepG2 cells, Mouse embryonic fibroblasts. Positive WB detected in mouse skeletal muscle tissue, human brain tissue. Observed molecular weight by Western-blot: 170-180kd
-
Tested applications
ELISA, WB, IHC, IF
-
Species reactivity
Human,Mouse,Rat; other species not tested.
-
Alternative names
AC III antibody; AC3 antibody; ADCY3 antibody; adenylate cyclase 3 antibody; Adenylate cyclase type 3 antibody; Adenylate cyclase type III antibody; Adenylyl cyclase 3 antibody; ATP pyrophosphate lyase 3 antibody; KIAA0511 antibody
-
Isotype
Rabbit IgG
-
Preparation
This antibody was obtained by immunization of Peptide (Accession Number: NM_004036). Purification method: Antigen affinity purified.
-
Clonality
Polyclonal
-
Formulation
PBS with 0.02% sodium azide and 50% glycerol pH 7.3.
-
Storage instructions
Store at -20℃. DO NOT ALIQUOT
-
Applications
Recommended Dilution:
WB: 1:200-1:2000
IHC: 1:20-1:200
IF: 1:20-1:200
-
Validations

mouse skeletal muscle tissue were subjected to SDS PAGE followed by western blot with Catalog No:107780(ADCY3 antibody) at dilution of 1:300
Immunohistochemical of paraffin-embedded human kidney using Catalog No:107780(ADCY3 antibody) at dilution of 1:100 (under 10x lens)
Immunohistochemical of paraffin-embedded human kidney using Catalog No:107780(ADCY3 antibody) at dilution of 1:100 (under 40x lens)

Immunofluorescent analysis of MDCK cells using Catalog No:107780(ACIII Antibody) at dilution of 1:50 and Alexa Fluor 488-congugated AffiniPure Goat Anti-Rabbit IgG(H+L)
-
Background
ADCY3 is an adenylate cyclase (AC) functioning to convert ATP to cAMP in response to signals initiated by activation of Gs-coupled receptors. To date, 10 isoforms of AC have been cloned in mammals. Initially identified in olfactory cilia, ADCY3 is regarded as the olfactory isoform and required for detection of odorants. Recently it has been found that outside of the olfactory epithelium the olfactory-like signaling pathway including AC3 may also have a key role in spermatogenesis and spermatozoa functions. In addition, the ciliary location of AC3 makes it as a prominent marker for primary cilia in brain.AC3 is typically found at 130 kDa in olfactory tissues.In nonolfactory tissues (such as sperm), this protein is reported to migrate with a molecular mass of 55 kDa,occasionally accompanied by additional bands at either 90 or 130 kDa(PMID:9539154).
Related Products / Services
Please note: All products are "FOR RESEARCH USE ONLY AND ARE NOT INTENDED FOR DIAGNOSTIC OR THERAPEUTIC USE"
